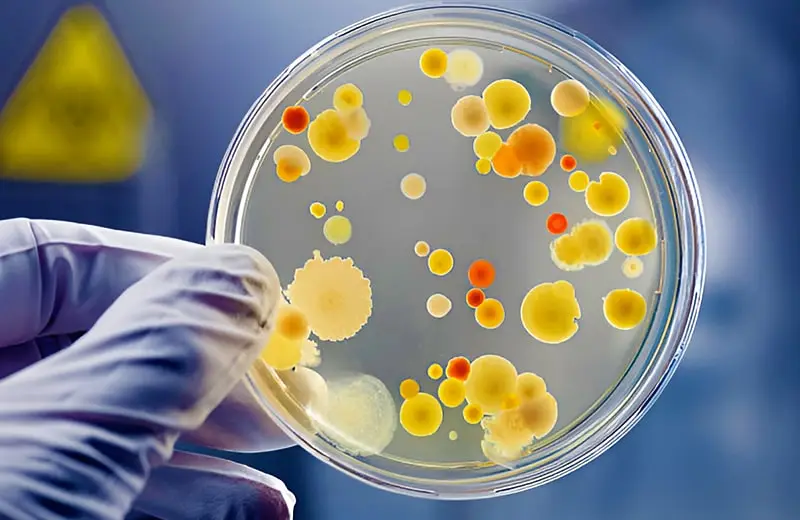

Microbiology laboratory tests identify bacteria, fungi, parasites, and viruses, guiding physicians in selecting effective treatments. These tests include antibiotic sensitivity testing, ensuring targeted therapy for infections and contributing to better patient outcomes by combating antimicrobial resistance.